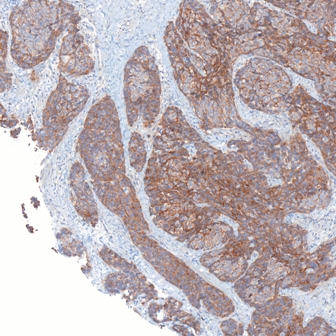
Her2 1

Definiens Brings Big Data to the Tissue
By Aaron Krol
February 5, 2014 | This Monday, an unusual partnership was announced between Clarient Diagnostic Services, one of the largest cancer testing facilities in the US, and Definiens, a software company that specializes in applying big data analytics to biomedical information. Clarient will be using a suite of thirteen Definiens-built tests at their CLIA-certified laboratory in Aliso Viejo, CA, to better classify patient samples in tests for breast cancer.
There’s nothing new about using big data in cancer testing. Massive troves of information on tumor genetics have become important resources in oncology, and several common genetic mutations have been shown to affect what drugs and courses of therapy a given cancer case is likely to respond to. More recently, a series of companies – most prominently Foundation Medicine, but also MolecularHealth, GenomOncology, and others – have cropped up to sequence tumor genomes and use big data techniques to match patients’ personal mutation profiles to best treatments.
What’s different about Clarient’s new partnership is that Definiens doesn’t work with genomes. That’s usually a given when anyone mentions “big data” in the context of biomedicine, but at Definiens, genomics is viewed as just one segment of a large and interconnected ecosystem of personal health data.
“There has been great progress made in genomics, but we have also learned that there are limitations,” says Definiens CEO Thomas Heydler, a serial entrepreneur who has helmed a series of computer science firms in Germany and the US. “It’s not clear in all cases how a gene mutation will translate into proteins, and into tissue, and so the tissue and the phenomic information is still to a large extent the gold standard for doing the diagnosis of a patient. That’s what a pathologist does all the time.”
Computational tools are getting better and better at drilling through the human genome for sources of variation, but the mission of translating that variation into real knowledge about personal health has proceeded more slowly. Definiens is working in the opposite direction, by entering a field – visual analysis of tissue samples – that already has serious diagnostic power, and trying to build computational tools that can keep pace with our existing knowledge.
“We really want to get this idea across,” Heydler told Clinical Informatics News, “that there is a complementary place to genomics, which is called ‘tissue phenomics.’ And those together create a very powerful diagnostic footprint to come up with much better diagnostics, and finally, much better treatment decisions.”
“Tissue phenomics” is Definiens’ term for all the data that exists in tissue samples: the shape and size of different cells, what stains and probes they take up, how they connect to one another – all the biomarkers that pathologists routinely use to turn microscope images into diagnoses. By building sophisticated image analysis software, the company hopes to automate the process of extracting this data from tissue samples, and expand what we know about which cellular traits can be used as biomarkers for different conditions. So far, Definiens has established itself as a world leader on the basic research side, with more than 50% market share in life sciences image analysis software, and customers in all of the twenty largest pharmaceutical companies.
The new partnership with Clarient, however, reveals a company ready to move into real clinical use.
Looking and Seeing
A computer has a lot of advantages over a human pathologist when examining images. It can process thousands of images at a time, rather than having to pore over photos one by one. It can precisely quantify data that a human may have to navigate by feel. It might record, for instance, that 65% of an image field is red, where a human observer would be limited to saying “most of it” is red.
But the human pathologist has one huge head start: she knows what she’s looking at. If what you want to know is how many cells took up a red stain, then the human being who can identify the different cells is in a much better position than the computer that can count the red pixels.
That’s the challenge Definiens set out to overcome. The company was founded in 1994 by Gerd Binnig, a Nobel Prize-winning physicist who, along with co-winner Heinrich Rohrer, led the IBM team that invented the scanning tunneling microscope, the first device to image individual atoms. Binnig wanted to build a software platform that could process images the same way the human brain does, with a basic understanding of what real-world objects an image corresponds to.
That platform is the Cognition Network Technology. “Instead of just having a pattern recognition and pixel-matching type of technology, we use a cognitive approach,” says Heydler. “We can teach the system about what we call context and knowledge, to really understand the objects it’s looking at.” Definiens software contains a treasury of important objects, and the shapes, textures and patterns by which they can be recognized. When it processes a new image, the Cognition Network Technology begins by dividing the photo into the objects it’s made up of. If the image is, for example, a CT scan of a human torso, the software will start by cataloguing the different organs, whose characteristics can then be considered separately. This object recognition is hierarchical, so the program can identify, for instance, both a single vertebra and a spine.
In tissue analysis especially, context is key to this task. “In a lot of images, you have the challenge that objects look the same, but depending on the context and where they are located, they have a totally different meaning,” says Heydler. “When you go into pathology, and look at the tissue images, a cell which is in an infiltration zone of a tumor, versus a cell in the healthy part of the tissue, looks exactly the same.” The Cognition Network Technology has to be trained not only to recognize the properties that define a cell, but also to understand where that cell belongs relative to other visual cues.
The object recognition features of Definiens software allow their platform to combine the contextual understanding of a human observer with the exhaustive analysis of a computer. A Definiens workflow can be narrowly set to a single task – “show which chromosomes took up this FISH probe” – but it can also simply record every feature of every object it sees, without running any particular assay. Definiens calls this “tissue datafication,” and it results in the same kind of messy jumble of information you see in whole genome sequencing.
“We create tremendous amounts of data,” says Heydler. “I would absolutely compare the data volume with the genomics data volume on a patient.” During clinical trials, Definiens customers use this tissue datafication to find novel biomarkers. They can place all the tissue samples from patients with a certain clinical outcome in one category, place all the samples with a different outcome in another, and let the program decide whether any similarities stand out. It’s the same process geneticists use to find mutations that contribute to complex conditions – except that the data, instead of coming in the form of As, Ts, Cs and Gs, might be membrane thickness or how closely packed the cells are.
“There’s tremendous value in the tissue,” says Heydler, “which is not uncovered yet because no technology was able to unearth the powerful information that sits in tissues. It was, so far, an analog science.”
Prognostics and Diagnostics
Working with pharmaceutical companies, Definiens has found clinical trials to be a major area of application for their software. The company often behaves like a CRO, providing one piece of the trial pipeline by analyzing tissue samples collected over the course of clinical studies.
Clinical trials increasingly involve a great deal of patient stratification, searching for particular patient groups that respond best to treatment. “Where a few years ago, a companion diagnostic was an afterthought,” says Heydler, “now companion diagnostics are co-developed together with the drug, ideally pulled together already in the clinical trials.” Tissue datafication, with its hoards of information that can be linked to outcomes, is a fast and effective way to find biomarkers for these companion diagnostics, which, if a treatment is successful, can be marketed together with the drug to find the best patient matches.
Especially in cancer treatments, where even the most successful drugs serve only a very narrow subset of patients, this trend is only likely to accelerate. “There are more than a thousand drugs in the pipeline right now for oncology,” says Heydler, “and at the end of the day, all of them, when they want to see the market, have to come up with patient stratification and companion diagnostics. So this is a major area of business momentum.”
As Definiens has gained experience developing these diagnostics, however, the company has come to see an opportunity to divorce these applications from clinical trials. There are plenty of treatments already available that could use better companion diagnostics, and plenty of labs looking for faster ways to process samples into meaningful information about patient health.
This week’s deal with Clarient, where Definiens software has been built into Clarient’s Scope IA Platform as part of immunohistochemistry testing in breast cancer cases, is an example of the kind of partnerships Definiens is seeking out to bring its image analysis capabilities into clinical use today. With its CLIA-certified lab, Clarient is able to clinically validate lab-developed tests, providing an ideal regulatory environment for a company like Definiens that deals in software, not commercial diagnostics.
Definiens is making a habit of partnering with CLIA reference labs for these clinical deployments. In November, the company announced another partnership with Cambridge-based Metamark Genetics, to use Definiens software in a prognostic test for prostate cancer at Metamark’s lab.
Prognostics are another promising area for applying tissue phenomics data to clinical testing. Metamark had realized that overtreatment for prostate cancer was rampant – an internal study had suggested that as many as 70% of patients who receive surgery or radiation therapy for prostate cancer could safely forego these disabling treatments, with regular monitoring to ensure the condition doesn’t worsen. The difficulty was discerning, from the standard formalin-fixed, paraffin-embedded tumor samples, which patients needed immediate treatment, and which could adopt a wait-and-see approach. For this, Definiens provided image analysis for Metamark’s ProMark test.
“What the Metamark test does, fully based on Definiens technology, is basically assessing a range of different immunohistochemistry stains, and combining that with a set of morphology markers that are read out of the tissue by Definiens,” says Heydler. “And that set or portfolio of markers is combined into a score,” which provides a clinically validated threshold for treatment.
“The test provides a lot of clinical value,” Heydler adds. “It reduces significantly patient pain, and it also reduces treatment costs.” The ProMark test is already being commercially deployed to help patients diagnosed with prostate cancer to better plan their care strategies.
With a large enough sample of tissue images from patients with different clinical outcomes, Definiens can very quickly suggest new biomarkers that show a relationship with the diagnosis or prognosis of disease. “We are able to add tests at a rapid speed based on the learning capability of the software,” says Heydler. “And that is unmatched in the industry.” He mentions prognostic tests in immunotherapy, and patient stratification for treatments centered on the PD-L1 protein, as promising areas under current development.
This growing interest in clinical settings had been reflected in corporate shifts at Definiens. Late last year, the company added two new positions to its management team: Pablo Jordan in the field of Clinical Digital Pathology, and Rebecca Berghorn as Director of Clinical Product Marketing.
“We are building more and more content, more and more applications, together with our partners,” says Heydler. “The goal is, once those tests are validated, to really bring them into the clinical market and commercialize them in the clinical setting. And in order to get there, we are evolving the company from being more a software-centric play, into much more of a bioinformatic play, and much more a diagnostic play.”
Heydler also holds open the possibility that Definiens may one day market tests for mass distribution on its own, seeking in vitro diagnostics approval from the FDA. For now, the company is reaching out to a number of new partners with their own CLIA labs, to help its diagnostic and prognostic tests reach patients quickly in a reliable environment.






